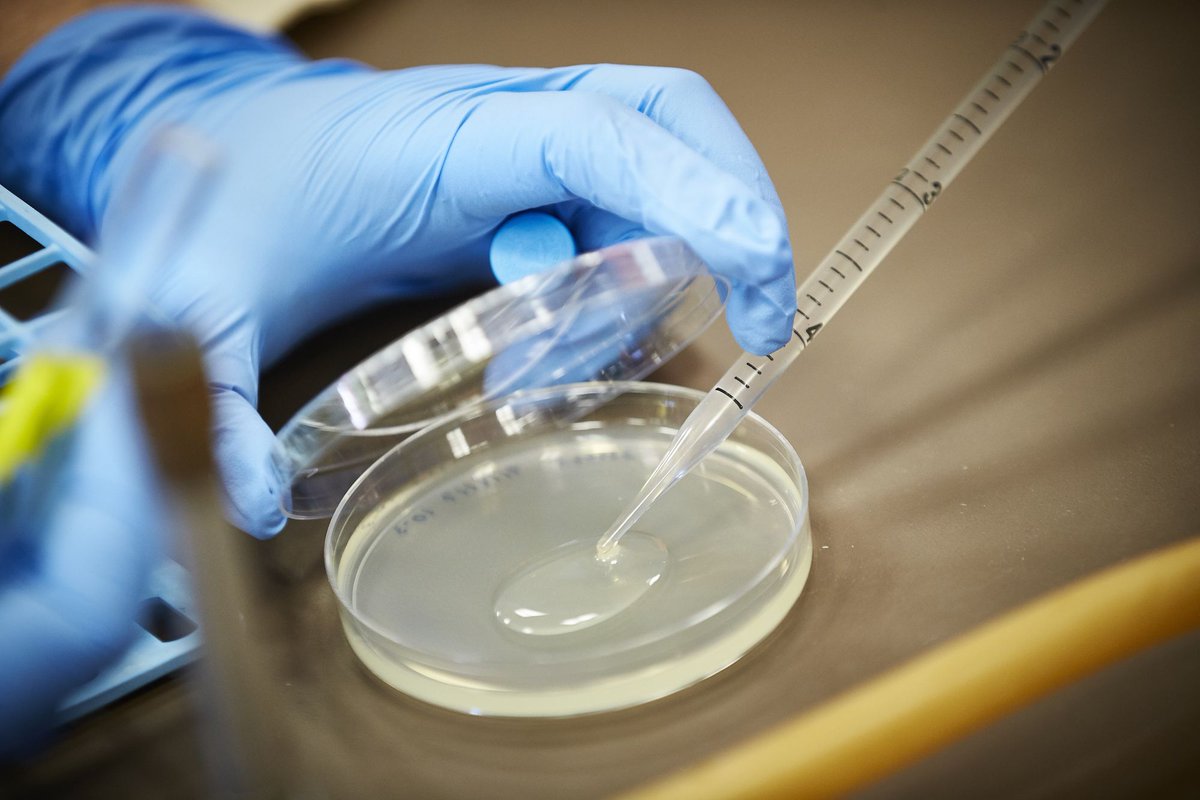
UNLV Research tweet media

We are hiring! Come join our team in the College of Education, Office of Research and Sponsored Projects. higheredjobs.com/details.cfm?Jo…
English
ORSPCOE
20 posts


@orspcoe
Office of Research and Supported Projects in the College of Education at the University of Nevada, Las Vegas.